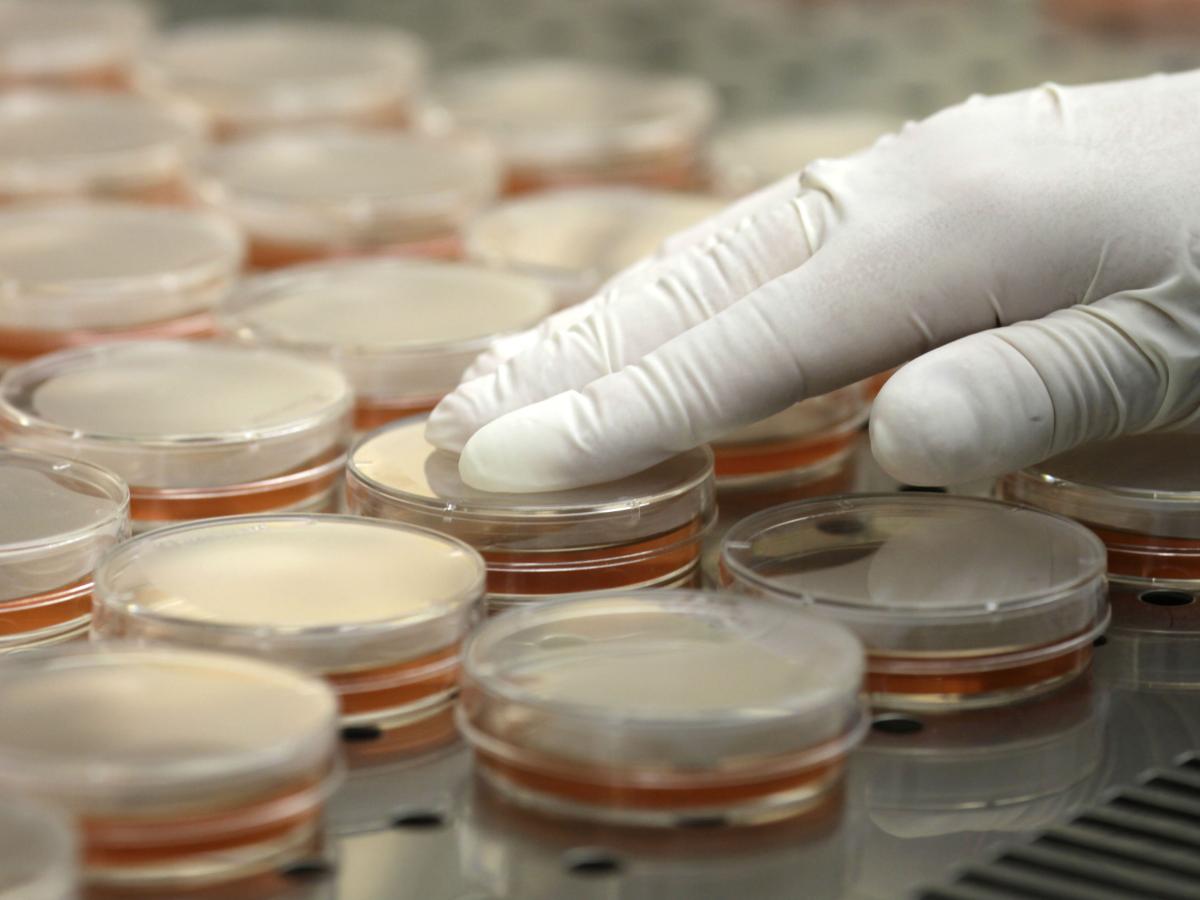

Contamination of high-touch surfaces is accountable for the transmission of pathogens in numerous settings. Its affect is most extreme at school and well being care amenities and is one cause why well being care-associated infections (HAIs) proceed to be such a major problem.
Though the variety of HAIs has been steadily lowering in the USA, “on any given day, about one in 31 hospital sufferers has no less than one well being care-associated an infection,” in accordance with knowledge from the U.S. Facilities for Illness Management and Prevention.
In class environments, contaminated surfaces not solely unfold illness inside school rooms but in addition can unfold infections, similar to influenza, inside a neighborhood.
The skilled cleansing trade performs an important function in stopping the unfold of an infection, however earlier than cleansing employees can get rid of pathogens, they have to first discover them. Prior to now, laboratory technicians would swab surfaces and use a petri dish tradition to substantiate the presence of pathogens. The findings wouldn’t be accessible for 2 to 4 days, giving the germs alternative to sicken extra folks.
Technological advances are offering faster strategies to find pathogens, enabling the skilled cleansing trade to raised meet its objective of defending human well being. Whereas these applied sciences have drawbacks, they do present promise.
Show Contamination With Paper Stickers
In Might 2019, a report within the Journal of the American Society for Microbiology discovered that paper stickers will be an efficient instrument to find out if contamination exists on surfaces. For as much as seven days, researchers positioned stickers on a number of high-touch surfaces in meals service areas. After analyzing the stickers, the researchers discovered they revealed a substantial buildup of contamination on these surfaces.
Paper stickers are a reasonable, easy, and efficient technique to find contamination. Nevertheless, the analyzation course of takes invaluable time, and the stickers solely choose up pathogens on the world examined, not the encompassing space.
ATP Marks the Spot
Though adenosine triphosphate (ATP) has been in use because the 1930s, it was first launched to the cleansing trade a couple of decade in the past. ATP monitoring programs detect residing cells on a floor. Customers merely swab a floor then place the swab contained in the ATP unit. Outcomes are normally accessible in about 20 seconds.
Whereas ATP doesn’t reveal which particular pathogens are on a floor, it serves as a purple flag that they might be current. Cleansing professionals use ATP to check a floor earlier than cleansing and once more after cleansing to find out cleansing effectiveness. Nevertheless, like paper stickers, ATP solely detects pathogens on the precise areas examined.
Imaging Paints a Large Image
The well being care trade, one of many first industries to make use of imaging know-how, discovered it helpful to seek out the expansion of most cancers and different abnormalities within the human physique. Within the skilled cleansing trade, staff use imaging applied sciences in colleges, meals service amenities, and well being care settings to take photos of a large space. These photos point out if pathogens are current primarily based on the colour, depth, and focus of photos proven.
Taking Duty for An infection Management
Whereas the plain cause for utilizing applied sciences like those talked about above is to rapidly discover and take away pathogens, cleansing professionals ought to be conscious that there’s something a lot larger at play right here.
Many germs are growing into superbugs that unfold ailments resistant to the drugs used to deal with them. Pharmaceutical corporations have set a restricted quantity of money and time in growing new antimicrobials. This places higher accountability on the cleansing trade’s shoulders to seek out and proactively eradicate dangerous pathogens. With these applied sciences and the implementation of efficient cleansing strategies, we will likely be as much as the problem.